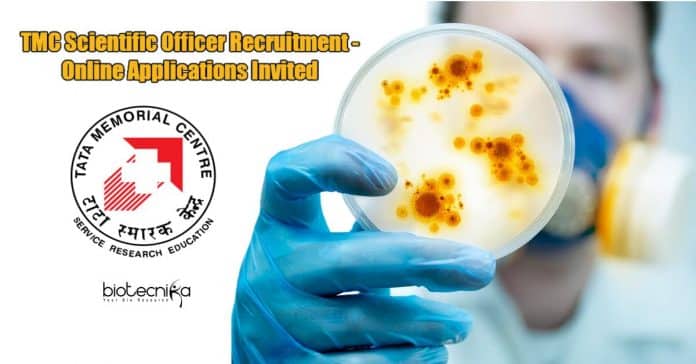

TMC Scientific Officer Recruitment – Online Applications Invited
Graduate in Botany/Zoology/Applied Biology Scientific Officer Jobs at Homi Bhabha Cancer Hospital/MPMMMCC Varanasi. TMC Scientific Officer Recruitment – Online Applications Invited. Scientific Officers job for bsc botany/zoology and applied biology candidates. Check out all of the details on the same below:
This call expires in :
Advt. No. VAR/2021/004
TATA MEMORIAL CENTRE
(A GRANT-IN-AID INSTITUTE UNDER DEPARTMENT OF ATOMIC ENERGY, GOVT. OF INDIA)
The Tata Memorial Centre (TMC) is a Comprehensive Cancer Centre with a mission to achieve the highest standards in patient care, cancer prevention, cancer research and professional development for oncology and also allied disciplines. TMC is an autonomous body funded, controlled by the Department of Atomic Energy, Government of India. TMC is affiliated to Homi Bhabha National Institute (HBNI). The HBNI is a Deemed University of the Department of Atomic Energy with a mission to develop high quality postgraduate educational programs in science as well as technology including those related to life and health sciences. TMC invites applications from eligible candidates of Indian nationality, that are keen to pursue a career in TMC. Full-time positions available in HOMI BHABHA CANCER HOSPITAL/ MAHAMANA PANDIT MADAN MOHAN MALVIYA CANCER CENTRE, VARANASI are listed below:
Job Name: SCIENTIFIC OFFICER ‘C’ (PATHOLOGY) – 02 (1UR, 1 OBC) (Online Application Form)
Age Limit: 35 years.
How to Apply:
(a) Last date for on-line application is 31.03.2021 up to 05.30 p.m.( Indian Standard Time).
(b) Applicants should send in their candidature through “On-line Application” only.
(c) Candidates will certainly be originally screened and called for Interview/ Written Exam/ Skill Test on the basis of the info provided by them in the on-line application form.
(d) Incomplete applications will certainly be summarily rejected.( e )Candidates who would be called for Interview/ Written Exam/ Skill Test are required to carry original documents alongwith one set of copy in support of the details furnished in the online application concerning date of birth, qualifications, experience, caste, disability certificate etc., failing which such applicants will not be allowed to appear for Interview/ Written Examination/ Skill Test.
(i) Date of Birth: Birth Certificate/ School leaving certificate/ S.S.C passing certificate.
(ii) Educational Qualification: Mark sheet & Passing Certification of the final examination.
(iii) Experience Certifications:
· Past Employment: Experience certification indicating the date of joining and relieving.
· Current Employment: Appointment letter, last Pay Slip, Identity Card.
(iv) Caste Certificate: Valid Caste Certification (in the format of Government of India), Caste Validity Certification in case of ST, Non Creamy Layer Certification in case of OBC applicants is mandatory. Formats are uploaded on TMC site.
(v) Economically Weaker section (EWS): Valid income certification (in format of Government of India) is obligatory.
(vi) Persons with Disability: Physical Disability Certification.
(f) Through Proper Channel: Persons working under Central/ State Government/ Autonomous Body/ Semi-Government Organizations and other Public Sector Undertakings must obtain the permission from their Head of the Organization to make an application for the post & to produce the very same at the time of Written Examination/ Skill Test/ Interview, failing which they shall not be allowed to appear for Interview/ Written Examination/ Skill Test.
(g) Referees: Three Referees listed by the applicant ought to have been associated with the training or supervision of the candidates work.
(h) Tata Memorial Centre reserves the right to fix minimum eligibility standard/ bench mark as well as restrict no. of applicants called for Written examination/ Interview/ Skill test taking into account various factors like no. of vacancies, percentage of marks in Grad/ Post Grad Degrees etc. Tata Memorial Centre additionally reserves the right to fix minimum eligibility standard/ cut-off marks (Group/ Stream/ Discipline/ Category-wise etc.) while finalizing such applicants to be called for Written test/ Interview/ Skill test as well as selecting the applicants for final selection after Written test/ Interview/ Skill test. The decision of the Director, Tata Memorial Centre in this regard shall be final as well as binding as well as no correspondence in this regard will certainly be entertained with the applicants.
(i) Tata Memorial Centre reserves the right to restrict the number of applicants called for the Written Exam/ Interview/ Skill test to a reasonable limitation, on the basis of qualifications and experience of the candidates. Mere fulfilling the prescribed qualifications will certainly not entitle a candidate to be called for Written Test/ Interview/ Skill test.
(j) In case it is found at any stage of recruitment that the candidate does not fulfill the eligibility criteria and also/ or, the applicant has furnished any inaccurate/ incorrect/ incomplete info or has reduced any material fact (s), his/ her candidature will certainly be terminated. If any shortcoming is detected, also after appointment, the services of the candidate are liable to be terminated forthwith. Therefore, before applying for any type of post, the candidate should make certain that he/ she fulfils all the eligibility criteria under the norms mentioned in the ad.
(k) Tata Memorial Centre also reserves the right not to call any type of applicants to appear for the Written exam/ Interview/ Skill test without assigning any reason there of.
(l) Canvassing in any kind of form will disqualify the candidature.
2. Age & experience will be reckoned as on the last date of submission of on-line application as mentioned above. Experience will certainly be reckoned post required qualifications.
3. Reservation of posts under various categories shall be applicable based on Govt. Rules.
4. For Inquiry: Applicants may email to [email protected]. No phone calls will certainly be entertained
5. Age Relaxation:
(a) Upper age is relaxable for persons belonging to Reserved Categories such as SC/ST/OBC/ PWD/Ex-servicemen & Other categories according to the instructions of Govt. of India as under:
05 Years: SC/ ST.
03 Years: OBC.
10 Years: PWD [additional 5 years in case of SC/ST & 3 years in case of OBC]
Ex-servicemen: length of service in Armed forces plus 3 years (additional relaxation in case of SC/ST/OBC according to the instructions of Govt. of India).
(b) Age relaxation maximum by 5 years for Departmental applicants, applicants with additional qualification and higher experience as well as applicants working in TMC on short-term basis/ under project/ on contract basis.
6. Application Fee:
(i) Applicant shall pay the application fee of Rs.300/- on-line utilizing Debit Card/ Credit Card.
(ii) SC/ ST/ Female Applicants/ Persons with Disabilities/ Ex-servicemen (first time applying for civil post after serving any ranking) are exempted from paying application fees.
(iii) The application fee paid will certainly not be refunded under any type of circumstances.
7. Applicants might be offered a higher or lower grade than what is advertised based on their working experience, research track record and also overall assessment at the time of interview and recommendation of the Selection Board.
8. Benefits:
(a) Allowances: Along with pay, other allowances including DA, HRA, TA etc. will certainly be admissible based on the prevailing guidelines of TMC.
(b) Training & Development: All officers will be eligible for institutional financial support for active participation in National and International Medical Meetings, Workshops, as well as Conferences after their probation, is closed.
(c) Medical Facility: Will certainly be admissible as per the prevailing guidelines of TMC.
(d) Accommodation: Residential accommodation will certainly be provided based on availability.
(e) Retirement Benefits: All are qualified for retirement benefits and pension under the New Pension Scheme.
9. Applicants appointed will certainly be rotated in any kind of Units of TMC (Tata Memorial Hospital, Mumbai, ACTREC, Mumbai, Homi Bhabha Cancer Hospital, Sangrur, Homi Bhabha Cancer Hospital & Research Centre, Mullanpur, Homi Bhabha Cancer Hospital & Research Centre, Vizag, Mahamana Pt.Madan Mohan Malaviya Cancer Centre( BHU), Varanasi, Homi Bhabha Cancer Hospital, Varanasi, BBCI, Guwahati on the needs of the Units concerned as and when needed.
10. The TMC additionally might exercise the option to offer appointments on “Contract Basis” for a fixed term on a consolidated remuneration.
11. Non Receipt of Application: Tata Memorial Centre does not take any kind of responsibility for non receipt of application through On-line.
12. Legal jurisdiction for any type of dispute will certainly be at Varanasi only.
Important Dates:
- Last Date of Online Application: 31/03/2021
Level: Level 10 [Pre-revised PB-3 (Rs.15600-39100) + Rs.5400 GP]
Level of Pay in Pay Matrix: Rs. 56,100/- Level 10, Cell 1 + Allowances applicable
Qualification & Experience:
M. Sc. (Botany/ Zoology/ Chemistry/Applied Biology) and preferably with a diploma in Medical Laboratory Technology from a recognized institute. Candidate must have at least 3 years experience in a responsible position of Histopathology of a large hospital/ Diagnostic centre. Candidates with experience in Immunohistochemistry Laboratory and proficiency in English language, computer skills and also that are well conversant with Accreditations associated process will be given preference.
APPLY ONLINE
Editor’s Note: TMC Scientific Officer Recruitment – Online Applications Invited. TMC Scientific Officer Recruitment 2021. Please make sure that you are subscribed to the Biotecnika Times Newsletter and our YouTube channel to be notified of all of the latest in the industry. Follow us on all of our social media like Twitter, Telegram, Facebook and Instagram.